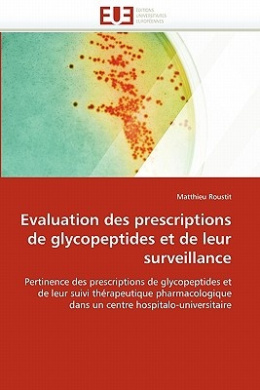
https://raw.githubusercontent.com/stevesteve2020-lab/img/refs/heads/main/h9jHvVxjLGJ2vD.jpeg

-
-86%
$57.00 Original price was: $57.00.$8.00Current price is: $8.00.
-
-68%
$41.00 Original price was: $41.00.$13.00Current price is: $13.00.
-
-94%
$116.00 Original price was: $116.00.$7.00Current price is: $7.00.
-
-82%
$78.00 Original price was: $78.00.$14.00Current price is: $14.00.
-
-83%
$87.00 Original price was: $87.00.$15.00Current price is: $15.00.
-
-87%
$119.00 Original price was: $119.00.$15.00Current price is: $15.00.
-
-93%
$102.00 Original price was: $102.00.$7.00Current price is: $7.00.
-
-82%
$79.00 Original price was: $79.00.$14.00Current price is: $14.00.
-
-88%
$77.00 Original price was: $77.00.$9.00Current price is: $9.00.
-
-89%
$63.00 Original price was: $63.00.$7.00Current price is: $7.00.
-
-89%
$70.00 Original price was: $70.00.$8.00Current price is: $8.00.
-
-74%
$53.00 Original price was: $53.00.$14.00Current price is: $14.00.